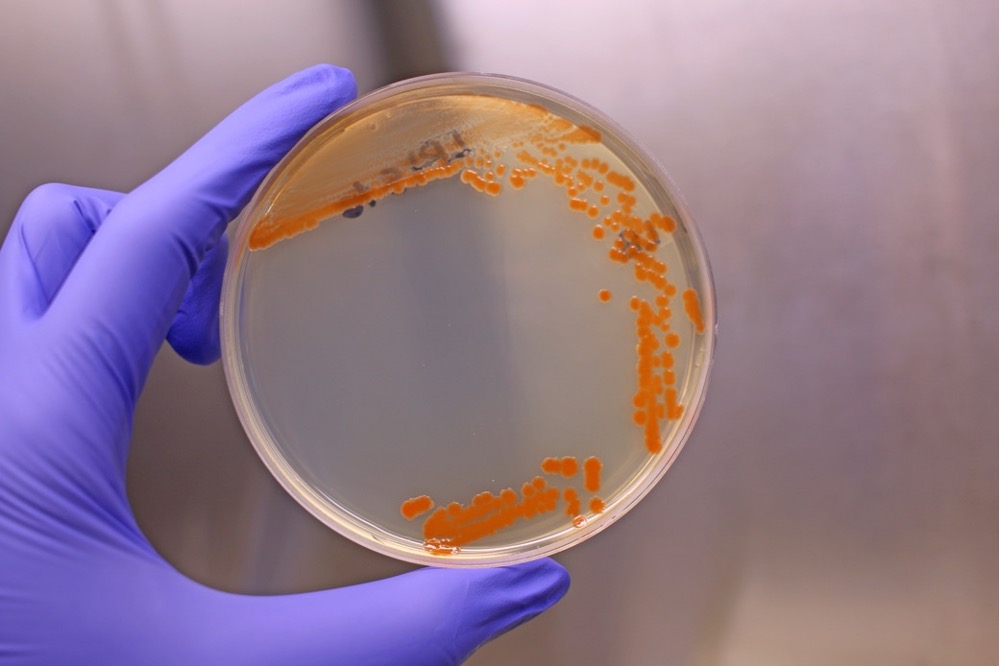
Alexandre Soares Rosado tweet media
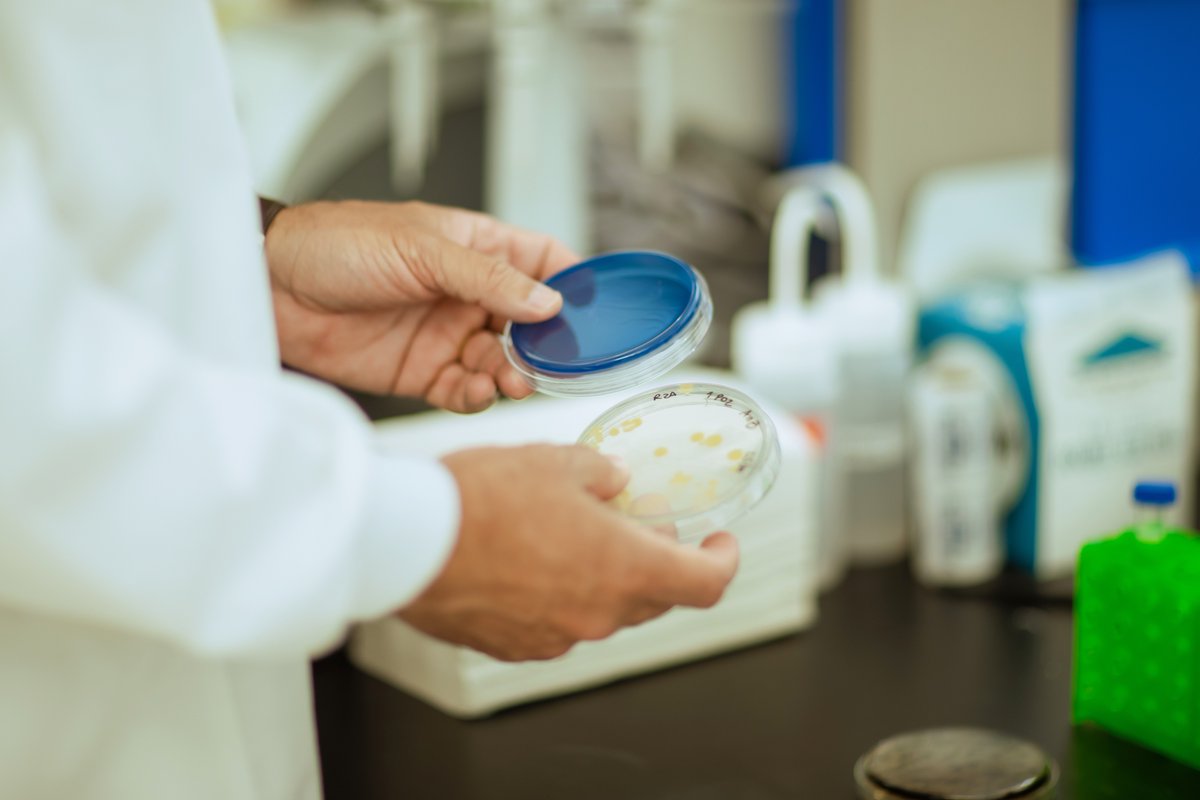
Alexandre Soares Rosado tweet media

Microbial EcoGenomics & Biotechnology Laboratory retweetledi

Discovering PETases: An Interlink Between Engineering Enzymes and Microbiomes - Jiménez & Rosado- 2026 - Environmental Microbiology - Wiley Online Library …icro-journals.onlinelibrary.wiley.com/doi/10.1111/14…
English